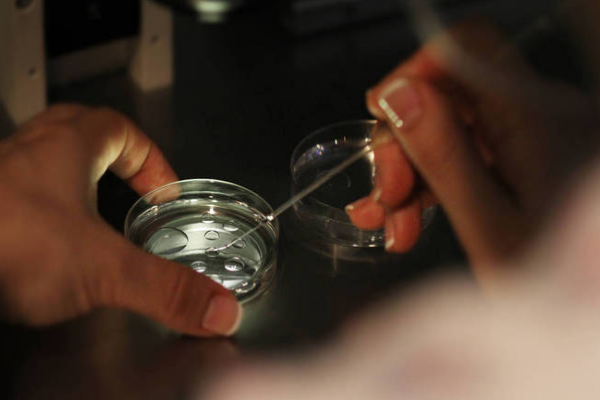
76cd8a7a5bc843061cf20e583334defb.png 如何应对试管失败

在生育的漫漫征程中,试管婴儿技术无疑为众多渴望拥有孩子的家庭点燃了希望之光。然而,现实中却有不少人深陷 “试管婴儿反复失败怎么办?” 的困境之中。这一问题犹如一块沉重的巨石,压在那些怀揣着父母梦的夫妇心头。试管婴儿反复失败,究竟是哪些因素在作祟?又该如何去破解这一难题呢?
试管婴儿是不孕不育家庭的希望,但并不是每位做试管的女性都能成功,约有很大一部分的女性会经历试管的失败。试管失败,可分为下列几种:
1.取卵失败
在进行男女双方的全面检查后,符合试管条件的女性,就进入试管周期。医生会给她们制定合适的促排卵方案。
但并不是每位女性都能如此顺利取卵成功。有的女性在促排过程中会出现促排反应不佳,获卵数少的情况;还有一些患者,促排卵针打了不少,最后不但没能达到促排目的,反而引发卵巢过度刺激综合征。
2.配不成胚胎
如果精子与卵子没有受精成为胚胎,那本周期的试管流程就是失败的,因为后续没有胚胎移植。
出现受精失败的原因大致有两种:
一是精子无法进入卵子,影响精卵正常结合。 二是当精子进入卵母细胞后,卵母细胞激活失败,导致受精卵无法分裂。
优秀的胚胎是试管成功的重要条件,不受精或受精而不卵裂都不能完成胚胎移植,也因而造成了试管婴儿的失败。

3.移植失败
移植环节,人人都希望能胚胎种植成功。但有的人移植了几次,总是失败。而导致移植失败的原因有:
胚胎发育潜能问题;
子宫内膜问题;
母体自身的因素;
免疫因素所导致的;
心理因素;
其他特殊原因等。
生化 / 胎停
移植后,有的人按捺不住心情,会自己验孕,看到验孕试纸上两条红线或一深一浅的红线,就开心雀跃,迫不及待想去医院确认。
但怀上了,在前3个月,还是很危险的。有一部分试管女性在此环节出现生化或者胎停,孕育之路戛然而止。
1. 针对取卵失败
①合适的促排方案
促排方案不是一个流水线作业,更不是所有人都一样,需要医生根据患者的身体情况,量身定做。
对于卵巢储备不好的患者,比如年龄已经超过了35岁,或者卵巢储备比较低,个体化治疗尤为重要。
所以在定方案的时候,大家一定要配合好医生做检查,只有掌握了身体的情况,才能定制出适合的方案,取得较好的结果。
②按时监测、谨遵医嘱
在促排过程中,一般需进行几次卵泡监测,具体需根据每个人的实际情况而定。每次监测后,医生会安排好下一次监测的时间,遵医嘱按时用药、复诊即可。
在试管婴儿卵泡监测过程中,不要擅自更改监测时间,更不要擅自停药,以免影响促排卵效果。
③务必按时“打夜针”
当监测结果提示卵泡接近成熟,注射HCG(也就是传说的夜针),促进卵子成熟,34-36小时后将卵子取出。
2. 配不成胚胎
卵子质量、精子质量都会影响胚胎质量,改善两者的质量就可以快速提高优质胚胎率。卵子精子的生长周期大概是三个月,所以至少提前三个月或半年就要把备孕工作做好。
3. 反复移植不着床
胚胎质量+子宫环境两者缺一不可。尽量移植优质胚胎,移植前处理子宫问题。听取医生的专业意见,勿盲目治疗。
4. 移植后生化/胎停
移植后生化/胎停需要及时去医院进行检查的,找出是不是胚胎质量不佳、母体激素水平紊乱、生殖道感染等因素导致的试管失败。如果是胚胎染色体异常,可通过三代PGT筛查出染色体正常的胚胎进行移植。
试管婴儿反复失败确实给人带来极大的心理压力与困扰,但请坚信,办法总比困难多。积极配合医生进行全面深入的检查和分析,不断调整治疗策略,保持乐观向上的心态,坚持不懈地努力,就有机会迎来属于自己的小生命,开启幸福美满的家庭新篇章。
相关资讯
更多>热门百科
更多>附近医院
更多>